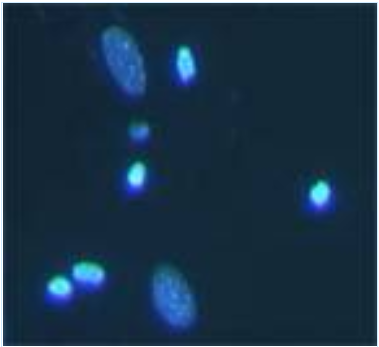
1587863169754613.png 细胞凋亡检测方法

8 年
手机商铺
公司新闻/正文
1295 人阅读发布时间:2020-04-26 16:32

细胞凋亡(apoptosis)是指细胞为了维持其内部环境的稳定,由基因控制的细胞自主有序的死亡过程,细胞凋亡是细胞的基本特征之一,在机体的胚胎发育、组织修复、内环境稳态等方面有着至关重要的重要。近年来,细胞凋亡研究领域不断深入,本文中,小编对实验室常用的检测方法进行整理,分享给大家!
一、形态学检测方法
借助普通光学显微镜、荧光显微镜或者透射电镜对培养的细胞、细胞涂片或者组织切片进行形态学观察。在实验室常用的是Hoechst染色,这是一种快速简便检测细胞凋亡的方法:细胞发生凋亡时,染色质会发生固缩,当用Hoechst33258染色后,利用荧光显微镜观察,正常细胞细胞核呈现正常蓝色,凋亡细胞的细胞核会致密浓染,颜色有些儿发白。以碧云天生物技术公司生产的Hoechst染色试剂盒为例,Hoechst染色检测细胞凋亡的步骤如下:
1.贴壁细胞
a.细胞爬片处理,使约为50%-80%满。
b.刺激细胞发生凋亡后,吸尽培养液,加入0.5mL 固定液,固定10min或更长时间(可4℃过夜)。
c.去固定液,用PBS或0.9%NaCl 洗两遍,每次3min,吸尽液体。
d.加入0.5mL Hoechst 33258染色液,染色5min。e.去染色液,用PBS或0.9%NaCl 洗两遍,每次3min,吸尽液体。
f.滴一滴抗荧光淬灭封片液于载玻片上,盖上贴有细胞的盖玻片。
g.荧光显微镜可检测到呈蓝色的细胞核。
2.悬浮细胞
a.离心收集细胞样品于1.5mL离心管内,加入0.5ml 固定液,缓缓悬起细胞,固定10min或更长时间(可4℃过夜)。
b.离心去固定液,用PBS或0.9%NaCl 洗两遍,每次3min。
c.离心后吸去大部分液体保留约50μL液体,再缓缓悬起细胞,滴加至载玻片上,尽量使细胞分布均匀。
d.稍晾干,使细胞贴在载玻片上不易随液体流动。
e.均匀滴上0.5mLHoechst 33258染色液,染色5min。用吸水纸从边缘吸去液体,微晾干。
f.去染色液,用PBS或0.9%NaCl 洗两遍,每次3min,吸尽液体。
g.滴一滴抗荧光淬灭封片液于载玻片上,盖上洁净的盖玻片,尽量避免气泡。
h.荧光显微镜可检测到呈蓝色的细胞核。
3.组织切片
a.常规包埋切片后,根据切片的不同类型,处理至可以用于免疫组化染色。
b.PBS或0.9%NaCl 洗两遍,每次3min,吸尽液体。
c.加入0.5mL Hoechst 33258染色液,染色5min。
d.去染色液,用PBS或0.9%NaCl 洗两遍,每次3min,吸尽液体。
e.小心将切片置于载玻片上,滴一滴抗淬灭封片液,盖上一洁净的盖玻片,尽量避免气泡。
f.荧光显微镜可检测到呈蓝色的细胞核。

正常细胞核
刺激后有致密浓染的凋亡细胞
二、流式细胞术检测方法
在实验室中,借助流式细胞仪和Annexin Ⅴ/PI凋亡检测试剂盒可以将凋亡早期的细胞、晚期的细胞以及死细胞区分开来。
流式检测细胞凋亡的操作步骤:
1. 细胞样品的准备
a) 对于贴壁细胞:小心收集细胞培养液到一离心管内备用。用不含EDTA的胰酶消化细胞,至细胞可以被轻轻用移液管或枪头吹打下来时,加入前面收集的细胞培养液,吹打下所有的贴壁细胞,并轻轻吹散细胞。再次收集到离心管内,1000rpm左右离心5min,沉淀细胞,对于特定的细胞,如果细胞无法完全离心至离心管底,可以适当延长离心时间或稍稍加大离心力。小心吸除上清,可以残留约50μL左右的培养液,以避免吸走细胞,加入约1mL 4℃预冷的PBS,重悬细胞,再次离心沉淀细胞,小心吸除上清。
b) 对于悬浮细胞:1000rpm左右离心5min,沉淀细胞,对于特定的细胞,如果细胞无法完全离心至离心管底,可以适当延长离心时间或稍稍加大离心力。小心吸除上清,可以残留约50μL左右的培养液,以避免吸走细胞,加入约1mL 4℃预冷的PBS,重悬细胞,再次离心沉淀细胞,小心吸除上清。
2. 用去离子水按1:3稀释结合缓冲液(4mL 4X结合缓冲液+12mL去离子水);
3. 用1X结合缓冲液重悬细胞,调节其浓度为1.5*106/mL;
4. 取100μL的细胞悬液于5mL 流式管中,加入5μL Annexin V/FITC混匀后于室温避光孵育5min;
5. 加入10μL 20μg/mL的碘化丙啶溶液(PI),并加入400μL PBS,立刻进行流式检测。
实验员正在借助流式细胞仪检测细胞凋亡
三、AO/EB双荧光染色法检测细胞凋亡
Acridine Orange属于三环杂芳香燃料,可以标记DNA、RNA,属于异染性荧光染料,AO常用于细胞内DNA和RNA进行检测。AO嵌合到双链DNA分子中显绿色,与DNA单链或RNA结合时发橙红色荧光。Ethidium Bromide嵌合到双链DNA或RNA的碱基对中,无碱基特异性,发红色荧光。AO可透过活细胞膜,EB不能通过与活细胞膜具有相同通透性的细胞膜。以北京雷根生物技术有限公司生产的AO/EB双荧光染色试剂盒为例,AO/EB双荧光染色检测细胞凋亡的步骤如下:
1、收集细胞,用PBS清洗细胞1次,加入适量的PBS重悬细胞,计数并调节细胞浓度至(1-5)*106/mL;
2、配制AO/EB工作液:取适量的试剂(A)、试剂(B)、试剂(C),按照试剂(A):试剂(B):试剂(C)=1:1:8的比例稀释配制成AO/EB工作液;
3、每25-50μL细胞悬液中加入AO/EB工作液2μL,混合均匀,室温孵育5-15min;
4、取洁净载玻片,滴加上5-10μL细胞悬液,轻轻盖上盖玻片;
5、用荧光显微镜进行观察。
细胞凋亡检测的方法有很多,可根据样本情况并结合课题要求选择合适的方法来验证。
关于MDL
MDL(Medical Discovery Leader)聚焦于医学科学基础研究与转化医学的研究,服务于国内以及国外科研人员,为疾病的诊断、预防、治疗提供研究基础。自有实验室超过6000平米,主营业务范围涵盖模型动物、细胞生物学、分子生物学、蛋白、病理学。经过10余年的发展,我们与国内超过百余家的研究机构上千名研究人员共同完成了12000+的实验项目。